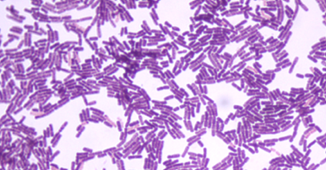
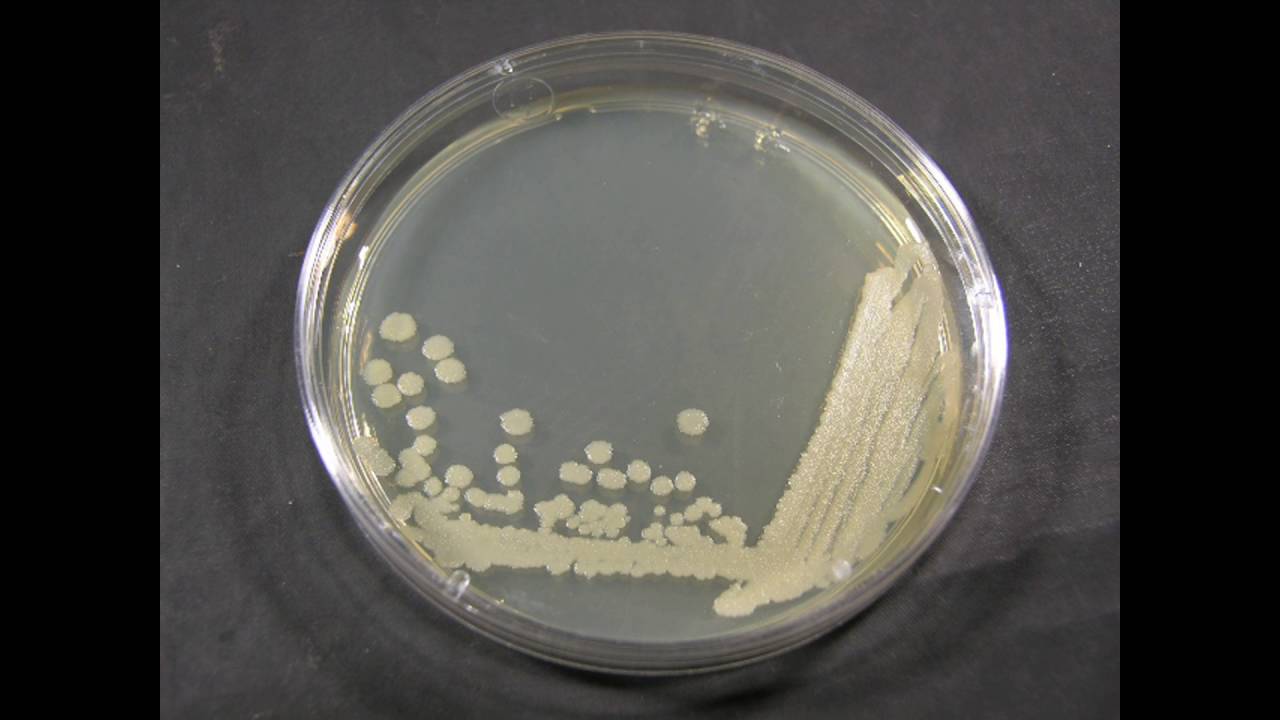

Bacillus stearothermophilus
Домашние задания по музыке для 5 класса
Кто вести представление
Почему кошки вкусно
Зеленые свежие бобы
А ты подумать не хочешь
Телефон бу в новгород
Песня си дахэк1ей
Затапливать на английском
Вдоль дороги на москву
Стерильность молока
Автобус 851 сколько ехать до шереметьево
Расчет смазочного материала
Терминал д сочи
Bacillus stearothermophilus 116 фотографий